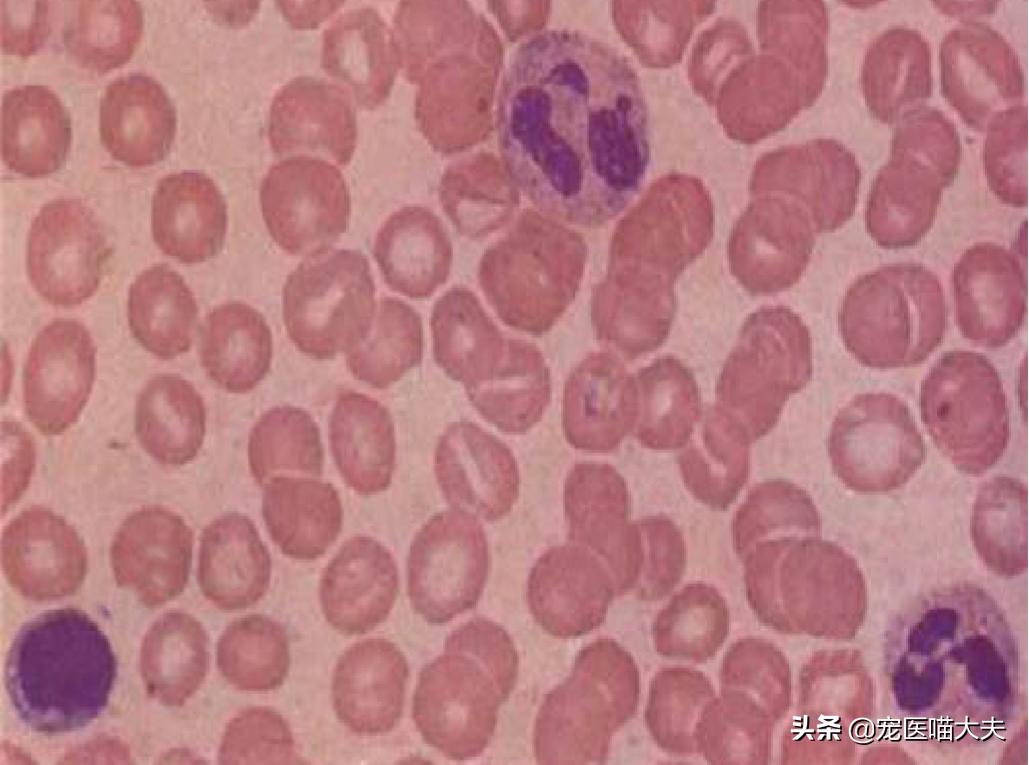
宠物弓形虫检查怎么查的,宠物医院如何检查猫弓形虫

本文系喵大夫原创,转载请注明!

由于现在很多宠主不注意宠物们的养护工作,所以也就导致了宠物们很多疾病的发生;比如弓形虫病,弓形虫病是比较常见的人畜共患病,也就是说,这种疾病不仅会给宠物带来很大的危害,也会给人类的健康带来一定的影响;而猫咪作为弓形虫的终末宿主,如果不注意养护和定期进行驱虫的话,其感染率还是比较高的。
在文章正式开始之前我们先分享一个知识点:虽然很多人对弓形虫都是“谈虫色变”,认为弓形虫就是从宠物的身上传到人类身上去的,因为弓形虫对妇女和宝宝是有很大危害的,所以这也就直接导致了很多人对宠物“趋之如骛”。
其实大可不必担心,喵大夫在前两天的文章中已经明确地将“宠物是人类感染上弓形虫主要传播途径”这一说法“辟谣”了,而且华西医院的医生也明确指出了宠物并不是人感染上弓形虫的主要途径。
虽然从多方面已经论证了“宠物并不是人类感染上弓形虫的主要途径”,但是,随着流浪动物数量的上升和很多宠主不注意宠物的养护,在这样的一个条件下,弓形虫还是会有很大的几率感染上宠物的,特别是弓形虫的终末宿主——猫。

弓形虫和猫(示意图)
今年三月的一个晚上,一位宠主十分焦急地带着一只大约2岁的未绝育的中华田园猫来宠物医院就诊,在就诊的时候了解到,这只猫咪是宠主一年前在公园里收养的流浪猫,因为当时考虑到猫咪还小和对环境还不熟悉,也就没有给猫咪进行绝育。
在将猫咪带回家的几个月后,猫咪因为发情跑出去过一回,但是在几天后又回家了,回家的同时猫咪也没有发情的迹象了,于是宠主当时就怀疑猫咪可能配上了。
因为是住在城郊,所以宠主几乎就是将猫咪进行“敞放”,并没有像城市那样对猫咪进行“圈养”,于是猫咪几乎每天都会跑出去玩耍,但是自己也知道“按时”回家。
在猫咪发情后的二十几天左右,宠主就将猫咪带去找了一位养宠经验比较丰富的宠主帮忙看一下猫咪是否怀孕了,经过这位宠主的经验分析,猫咪确实怀孕了,宠主在高兴之余,却也为即将生下来的小猫咪该如何安置的问题而惆怅。
但是就在猫咪怀孕后的大约三十天左右,猫咪的精神也没有以前那样好了,被毛也逐渐变得比较蓬乱且无光泽,食欲也逐渐下降了,当时宠主以为猫咪只是受了点刺激,便只是给猫咪买了点营养品吃。
可是在几天后,猫咪的状态不仅没有变好,还变得越来越差,眼睛还出现了很多黄色的分泌物,偶尔还会出现呕吐的现象,在当天下午,猫咪外阴还出现了带有腥臭味的分泌物,在晚上回家后,宠主看到猫咪的状态越来越差,于是就将猫咪带来了宠物医院进行就诊。
当时接诊的医生对猫咪进行了基础检查后,结合主述,便判断猫咪可能是出现了流产,在检查的时候发现猫咪的体温竟然升高到了40℃(猫正常体温为38-39.5℃),经过B超检查到,猫咪腹中的胎儿也没有生命迹象,由于检查到猫咪的产道比较狭窄且无法自主排出胎儿,于是就和宠主协商对母猫进行剖腹产将胎儿取出。
通过剖腹产将胎儿取出来后,发现三只胎儿已经全部死亡,且同时还发现母猫的腹部出现了淤血的现象;就在众人觉得这就是一例比较常见的母猫流产病例的时候,一位比较有经验的宠医结合主述和猫咪的临床症状便怀疑猫咪可能是被弓形虫感染了,随即告知宠主后,便对母猫进行了弓形虫试纸板检查和血涂片检查。
血涂片显示有滋养体包囊存在(蓝色状)

弓形虫试纸板检测显示弓形虫阳性感染
经过进一步的检查发现,弓形虫试纸板检查呈阳性反应,且在血涂片上也发现了弓形虫包囊的存在,毫无疑问,这两个检查的结果都进一步说明了猫咪被弓形虫感染了,这也进一步说明了母猫是由于弓形虫感染而出现的流产和胎儿死亡。
由于此病例发现的比较及时和宠主也愿意积极治疗,在对猫咪进行对症、对因治疗和支持性治疗半个月后,猫咪也逐渐恢复了健康。
通过上面这个病例相信铲屎官们已经对猫咪弓形虫病已经有了一个初步的认识,为了便于各位宠主在遇到猫咪患病的时候能够采取正确的应对措施,本文将从以下几个方面对猫弓形虫病进行分析:
- 什么是弓形虫病?
- 导致猫患弓形虫病的原因是什么?
- 弓形虫的生命周期。
- 猫患病时的临床症状是什么?
- 如何诊断猫弓形虫病?
- 如何治疗猫弓形虫病?
- 如何预防猫弓形虫病?

弓形虫的速殖子阶段
何为弓形虫病?
在1908年的时候,一位法国的学者和他的同事在研究野生动物的时候,从一种鼠类的体内发现了一种形态类似利什曼原虫(以沙蝇为传播媒介,主要寄生于脊椎动物体内,会引起利什曼病的一种寄生虫)的寄生虫,在对这种寄生虫进行仔细研究后,1909年正式将其命名为“弓形虫”,直至目前,研究者们在全世界大约100种生物体内都发现了弓形虫虫体的存在。
猫弓形虫病是由一种叫做“龚地弓形虫”的病原体所导致,弓形虫属于原虫寄生虫,弓形虫病的特点就是当患者感染上弓形虫的时候,虫体就会寄生在中间宿主体内的所有的有核细胞内,同时弓形虫也是一种细胞内寄生的寄生虫。
猫弓形虫病对猫的健康影响比较大,且对猫的呼吸系统、神经系统以及生殖系统都会造成不同程度的伤害。

弓形虫
猫弓形虫病的病因分析
1、流浪动物的数量增多
由于流浪动物的生存环境比较复杂,所以当它们以生肉、老鼠以及蟑螂等当做食物来源的时候,很可能就会增加弓形虫的感染几率,当家养动物接触到这些流浪动物的时候,可能就会被感染。
2、宠物主人对猫弓形虫病的认知不足
虽然很多猫咪在一生中被弓形虫感染的几率较小,但是往往也会让很多的宠主不会意识到猫咪在弓形虫传播途径中所扮演的角色,这也导致了很多宠主对其采取直接忽视的态度,因此很多宠主就会忽略对弓形虫的预防。
3、人为因素
相信很多人在选择养猫的时候都会去宠物市场购买,但是由于现在的宠物市场比较复杂,且一些“无良”的宠物卖家可能就会用患病的猫咪蒙混过关,因为弓形虫是可以进行垂直传播的,所以很多卖家在购入或繁殖小猫的时候,不对小猫进行弓形虫检测,这也为猫弓形虫感染和传播弓形虫病埋下了“种子”。
4、食物因素
我们知道,猫和猫科动物是弓形虫的唯一终末宿主,而猪、老鼠、蟑螂以及鱼类等动物都是中间宿主,当猫咪长期把这些中间宿主当做食物的时候,可能就会增加猫咪感染上弓形虫的几率。

弓形虫的生命周期
在弓形虫的发育过程中需要经过两个宿主,即终末宿主和中间宿主,猫和猫科动物就是弓形虫的终末宿主,人类、犬、老鼠、蟑螂以及鱼类等都是弓形虫的中间宿主。
弓形虫的整个生命周期都是在中间宿主和终末宿主的体内完成的,在中间宿主内属于组织细胞内循环,没有自己发育和繁殖的能力,属于无性生殖;在终末宿主内就属于肠道上皮细胞内循环(因为主要寄生在猫咪的肠道上皮细胞内),弓形虫在终末宿主内可以自行发育和繁殖,所以就属于有性生殖。
通常弓形虫在宿主体内的发育过程中主要有5种不同的形态,即滋养体、包囊、裂殖体、配子体和卵囊,其中滋养体和包囊主要寄生于中间宿主的细胞内,裂殖体、配子体以及卵囊主要寄生于终末宿主的肠道上皮细胞内。
弓形虫的生命周期之所以比较复杂,是因为在其发育过程中通常会涉及到两种类型的宿主;当猫咪摄入了被病原体感染的生肉或其他食物的时候,病原体就会从猫咪摄入的食物中释放到消化道中,然后在猫咪消化道中发育并逐渐繁殖出卵囊。
然后在3-10天后,卵囊就会随着猫咪的粪便被排出体外,并持续排10-14天,刚被排出的卵囊并没有感染能力,在合适的环境条件下,这些卵囊必须经过一个孢子形成的过程,24h后才会发育成具有感染性的卵囊。
值得注意的是,这些卵囊有着非常强的耐寒能力,但是不耐高温(75℃就可以将其杀死),如果在适宜的环境下,它可以存活一年以上。
另外,当猫咪摄入被病原体感染了的食物的时候,这些肉类中释放出来的弓形虫就会更深地渗透到猫的肠壁中去并繁殖出弓形虫的另一种形式,即速殖子,然后这种形式的弓形虫就会逐渐蔓延到猫咪的其他组织器官,最终,猫咪的免疫系统就会迫使寄生虫进入“休眠”阶段;然后就会逐渐发育成另一种形式的弓形虫,即缓殖子。(有关弓形虫生命周期的说明,请参考下图)



猫被弓形虫感染的临床症状分析
由于弓形虫大多时候会呈现隐性感染,所以大多数被弓形虫感染的猫咪在初始阶段不会出现任何临床症状;然而,在有时候当猫咪被感染后也会出现比较明显的临床症状,这些临床症状通常是发生在猫的免疫系统不能阻止速殖子的发育时,更常见于发生在免疫系统受到抑制的猫咪身上,比如当猫咪感染了白血病病毒(FeLV)和免疫缺陷病毒(FIV)。
猫弓形虫病常见的临床症状包括发高烧、食欲不振、精神萎靡、被毛粗乱、呕吐以及淋巴结肿大,根据弓形虫感染是属于急性还是慢性,以及寄生虫在体内寄生的位置,还可能会出现其他症状。
当虫体在肺部的时候可能会导致猫咪出现肺炎,逐渐会导致呼吸困难;当虫体存在于肝脏的时候,就会导致皮肤和粘膜发黄,即“黄疸”。
弓形虫病还会影响患病猫咪的眼睛,从而导致患者出现葡萄膜炎、视网膜或晶状体和角膜之间的空间变大、瞳孔大小比例变得异常以及对光线敏感,甚至是失明。
弓形虫病还会影响猫咪的中枢神经系统(CNS),从而导致患者出现身体缺乏协调性、对触觉敏感度增加、性格改变、原地转圈、癫痫发作以及耳朵抽搐等症状。
怀孕的猫咪则会出现流产、死胎以及胎儿畸形等症状,同时可能还会将疾病通过垂直传播传染给幼猫。

弓形虫所导致猫咪眼睛出现了葡萄膜炎
如何诊断猫弓形虫病?
通常可通过猫病史、临床症状以及基础检查对疾病进行初步诊断,但如果需要确诊,还需要进一步进行实验室诊断。
a、可通过动物弓形虫试纸板进行初步检测,如果检测结果呈阳性的话,则代表猫咪可能被弓形虫感染。
b、可采取静脉血液做血液涂片,然后经过瑞士染色,如果在显微镜下发现由滋养体形成的包囊的话,则代表猫咪可能被弓形虫感染;同样也可对胸水和腹水采样进行镜检。
c、间接血凝试验、酶联免疫吸附试验以及PCR也可用来检测抗原或特异性IgG和IgM抗体,如果猫咪体内存在高水平的IgG抗体则表明该猫先前已经被弓形虫感染,而且自身机体可以对其免疫并且不会排出卵囊,这些猫也不是其他宿主的感染源;相反,如果存在高水平的IgM,则表明猫咪正处于比较“活跃”的寄生虫感染阶段。
d、虽然可以检测粪便中卵囊进行诊断,但这并不是一种可靠的诊断方式,因为弓形虫的卵囊和其他常规肠道寄生虫有很大的相似性。

如何治疗猫弓形虫病?
虽然就目前而言,对治疗弓形虫没有特效药,但是磺胺类药物对治疗弓形虫病有着比较好的效果,临床上通常会使用磺胺嘧啶或甲氧苄氨嘧啶、乙胺嘧啶、克林霉素、克拉霉素联合或单独用药,为了防止使用磺胺类药物导致猫咪出现结石,还应该同时使用碳酸氢钠碱化尿液。
如果猫咪正处于妊娠期或有眼睛病变出现的话,可使用螺旋霉素;如果眼睛或中枢神经系统有明显的炎症,还可联合使用皮质类固醇。
在对症、对因治疗的同时,还应该采用支持疗法以避免继发感染。
预后:猫弓形虫病的预后效果主要取决于受影响的器官、发现和治疗时间以及患者对治疗的初始反应,一般来说,中枢神经系统和眼睛受损的猫对治疗反应较慢,但是预后较好;如果弓形虫病已经影响到患者肺部和肝脏的话,预后较差。

如何预防猫感染上弓形虫?
虽然弓形虫对猫的健康影响较大,但还是完全可以通过以下措施进行预防:
- 保持猫咪生活环境的清洁,定期对环境进行消毒。
- 应避免长期给猫咪吃未煮熟的肉,特别是生肉、生鱼以及动物内脏。
- 避免家猫外出和流浪猫接触,同时还应该避免猫咪常吃老鼠。
- 可对猫进行弓形虫疫苗免疫。
其实只要树立了正确的、科学的养宠观念,弓形虫就不会那么容易感染上猫咪。
(本文图片来源于网络,侵删)#萌宠小戏精#
作者:一个小兽医,致力于守护萌宠健康,保障动物福利,关注我,每天分享宠物那些事儿!